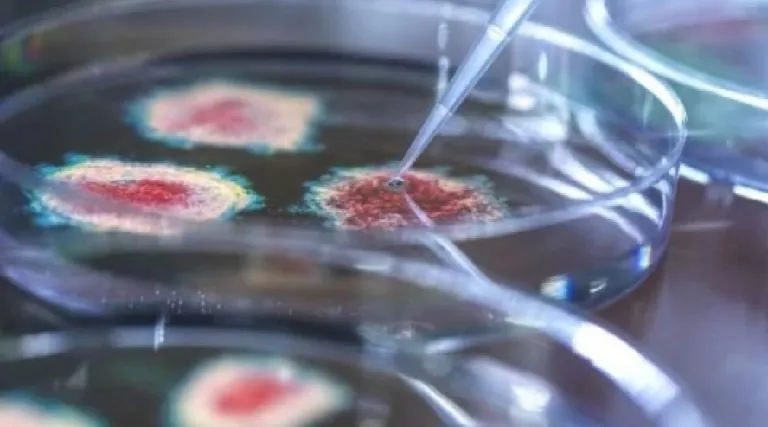

Pesquisadores da Universidade de Nebraska-Lincoln, nos Estados Unidos, descobriram o primeiro organismo vivo que se alimenta exclusivamente de vírus. O microrganismo Halteria é um tipo de plâncton encontrado em água doce.
A descoberta foi publicada na revista Proceedings of the National Academy of Sciences (PNAS), em novembro de 2022 após três anos de investigações. Os cientistas queriam entender se algum microrganismo podia comer vírus ativamente e se esta dieta poderia contribuir com o seu crescimento fisiológico ou de uma comunidade. Eles descobriram que sim.
Foram feitos testes em laboratório com amostras de água de um lago local com diferentes micróbios colocados em contato com o clorovírus, conhecido por infectar algas verdes microscópicas. Em dois dias, as populações de Halteria cresceram aproximadamente 15 vezes, enquanto os níveis de clorovírus caíram 100 vezes.
A marcação do DNA do clorovírus com corante fluorescente antes de ser introduzido na água comprovou que o vírus foi o responsável por impulsionar o crescimento de Halteria e aumentar o tamanho de sua população. Em pouco tempo as células de Halteria começaram a brilhar também.
“No início, era apenas uma sugestão de que havia mais (organismos Halteria), mas eles eram grandes o suficiente para que eu pudesse pegar alguns com a ponta de uma pipeta, colocá-los em uma gota limpa e contá-los”, afirma o ecologista John DeLong, um dos autores do estudo.
No artigo, os pesquisadores explicam que há uma ampla gama de organismos que se alimentam incidentalmente de vírus. Porém, esta é a primeira vez que se identifica um organismo que tem uma dieta composta exclusivamente de vírus.
Com informações Metrópoles